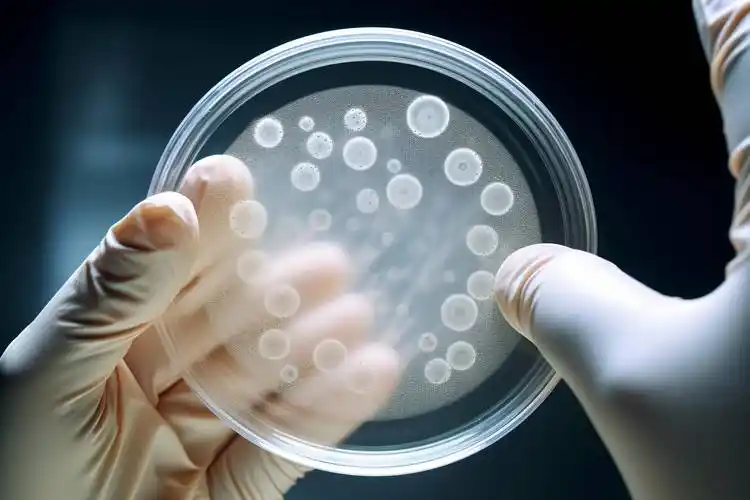
image

时间:2025-12-26 预览:0

无尘车间等级根据单位体积空气中特定粒径粒子的最大允许浓度划分,数字越小,洁净度越高。目前全球主流采用 ISO 14644-1 国际标准,中国国家标准 GB/T 25915.1(等效采用 ISO 标准)与 GB 50073-2013(洁净厂房设计规范)也广泛使用。此外,国内仍常用传统的“百级、千级、万级”等表述,三者可对应转换。
国际标准(ISO14644-1,等同GB/T25915.1) | ≥0.1μm粒子数(个/m³) | ≥0.5μm粒子数(个/m³) | ≥5μm粒子数(个/m³) | 对应传统级别 | 典型应用 | 对应美国209E(已废止) |
ISO1级 | 10 | 0.01 | - | 超高洁净 | 芯片制造(纳米级) | - |
ISO2级 | 100 | 0.35 | - | 十级 | 微电子、硬盘制造 | - |
ISO3级 | 1,000 | 3.5 | - | 百级 | 半导体、精密光学 | 1级 |
ISO4级 | 10,000 | 35 | - | 千级 | 光学镜片、小型电子元件 | 10级 |
ISO5级 | 100,000 | 352 | ≤2,930 | 万级 | 无菌灌装、医疗器械 | 100级 |
ISO6级 | 1,000,000 | 3,520 | ≤29,300 | 十万级 | 医药无菌包装、电子组装 | 1,000级 |
ISO7级 | 10,000,000 | 35,200 | ≤293,000 | 三十万级 | 食品灌装、非无菌药品 | 10,000级 |
ISO8级 | 100,000,000 | 352,000 | ≤2,930,000 | 百万级 | 一般电子组装、普通洁净区 | 100,000级 |
ISO9级 | 1,000,000,000 | 3,520,000 | - | 普通净化 | 包装、一般工业区 | 1,000,000级 |
专为医药生产设计,兼顾粒子数与微生物控制,仅适用于医药行业:
中国GMP级别 | 静态≥0.5μm粒子数 (个/m³) | 对应ISO等级 | 适用场景 |
A级 | ≤3,520 | ISO5级 | 无菌药品核心区(灌装、封口) |
B级 | ≤35,200 | ISO6级 | 无菌药品生产洁净区 |
C级 | ≤352,000 | ISO7级 | 非无菌药品高洁净区 |
D级 | ≤3,520,000 | ISO8级 | 非无菌药品一般洁净区 |
制药行业:GMP标准额外强调 粒子数与微生物限度 双重控制,洁净区分为 A、B、C、D 四级,动态监测要求严格;
医疗器械行业:执行YY0033-2000/ISO13485,常用 百级、万级、十万级、三十万级,同步管控微生物;
电子行业:侧重非活性粒子控制,对微生物无强制要求,核心区(如光刻)需 ISO 3–ISO 5,组装区可为 ISO 6–ISO 8。
ISO1-3级(超高洁净):半导体芯片制造(≤90nm工艺)、纳米材料生产、超高精度光学仪器、硬盘磁头制造、医药无菌制剂灌装核心区;
ISO4-5级(高洁净):光学产品加工、电子元件制造、无菌药品生产、高端医疗器械洁净区、巧克力/功能性食品等高端食品生产;
ISO6-8级(中高洁净):电子组装、PCB板制造、非无菌药品生产、乳制品包装等食品饮料加工、液压/气压系统制造、普通精密机械加工、化妆品灌装;
ISO9级(普通净化):普通工业洁净环境、包装材料生产、对洁净度要求较低的一般生产区域、仓库。
行业 | 推荐ISO等级 | 关键考量因素 |
微电子/半导体 | ISO1-5级 | 产品线宽越小,所需等级越高 |
医药/医疗器械 | ISO5-7级(A/B/C级) | 无菌要求越高,等级标准越严格 |
食品加工 | ISO7-8级 | 直接入口食品需更高洁净等级 |
光学/精密仪器 | ISO4-6级 | 镜片/仪器精度决定等级要求 |
一般电子组装 | ISO8级 | 仅需满足基础防尘需求 |
粒子浓度测量:使用激光粒子计数器,按标准方法在指定采样点采集数据,以特定粒径(0.1μm、0.5μm等)粒子数为核心指标;

状态区分:
空态:无设备、无人员的车间状态;
静态:有生产设备、无操作人员的状态;
动态:正常生产(设备运行、人员作业)的状态,要求最严格;
辅助参数要求:
温度:22±2℃;
湿度:45±10%;
压差:洁净室相对相邻区域≥5Pa(防止低洁净度空气流入);
换气次数:ISO5级≥240次/小时,ISO8级≥20次/小时(等级越高,换气次数要求越高)。
空气过滤系统:采用高效过滤器(HEPA)或超高效过滤器(ULPA),对进入车间的空气进行多级净化,拦截悬浮粒子;

气流组织设计:
单向流(层流):空气匀速单向流动,快速排除污染物,适用于ISO5级及以上高等级区域;
非单向流(乱流):空气不规则流动,通过稀释降低尘埃浓度,适用于ISO6级及以下区域;
压差与温湿度控制:维持洁净室正压环境,恒定温湿度在工艺要求范围,避免环境波动影响洁净度;
人员与物料净化:设置风淋室、更衣室、传递窗,严格管控人员着装(洁净服)、物料转运过程,减少外部污染带入;
建筑与清洁管理:采用光滑、不产尘、易清洁的围护材料;建立日常清洁、定期监测机制,配套人员专业培训。
核心原则:以产品工艺敏感度(微小杂质是否影响功能/安全)和行业法规要求(如医药GMP为强制性标准)为核心,平衡洁净需求与成本效益;

成本考量:洁净等级越高,建造、能耗(电费)、维护成本呈指数级增长,避免盲目追求高等级;
分区控制策略:仅在关键工序(如无菌灌装)使用高等级洁净区(如ISO5层流工作台),背景环境可采用较低等级(如ISO7-8级),降低整体成本。